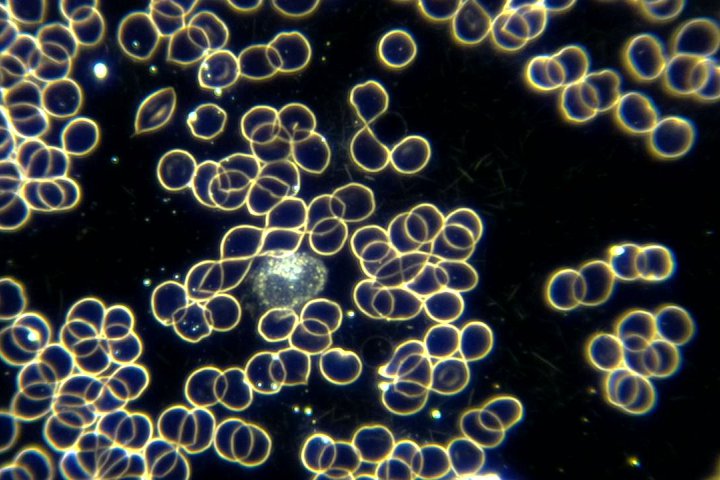

MicroBlue Mikroskope von Euromex
Diese Durchlicht-Mikroskope sind für den Einsteiger zu geringen Kosten und werden wegen ihrer Robustheit im Unterricht eingesetzt.
- Monokulare Modelle, binokulare und trinokulare Modelle mit einstellbarer 1 W NeoLED-Beleuchtung
- teilweise mit integrierter 1,3 MP Kamera und ImageFocus 4 Software
- Modelle mit integriertem LCD Display
- Alle Modelle verfügen über ein internes Netzteil/Ladegerät und 3 NiMH-Akkus
Broschüre MicroBlue
MicroBlue-Durchlicht-Mikroskope
Mikroskop für Kinder
Novex Junior (119,00€) bitte hier klicken:

EcoBlue Mikroskope
Die optische Leistungsfähigkeit der ergonomischen Euromex BlueLine Mikroskope ermöglicht lange produktive Arbeitssitzungen für Studenten, für Unterricht in fortgeschrittenen Wissenschaften. Mikroskope für die Ausbildung sind einfach zu bedienen und besitzen ein gutes Preis/Leistungsverhältnis.
- Monokulare, binokulare und trinokulare Modelle
- Achromatisch korrigierte Objektive
- regelbare 1 W LED-Beleuchtung mit interner Stromversorgung, teilweise mit internen Akkus
- Polarisationsmodelle sind standardmäßig mit Halogenbeleuchtung
- LED-Polarisationsversionen sind auf Anfrage erhältlich
- teilweise mit integrierter 3.2 MP Kamera und ImageFocus 4 Software
Broschüre EcoBlue

BioBlue Mikroskope für die gehobene Anwendung
Diese Mikroskopreihe für Bildungseinrichtungen und kleine Labore verfügt bereits über semiplanare achromatische Objektive mit sehr guten Abbildungseigenschaften.
- Die Grundmodelle sind teilweise erhältlich mit Polarisation als Trino oder integrierter 3,2 MP CMOS-Kamera.
- Das BioBlue EVO verfügt bereits über Semi-Plan Objektive, Köhler Beleuchtung und ist als Trino erhältlich.
- Modelle des BioBlue LAB sind teilweise ausgestattet mit Plan-Objektiven mit unendlich korrigierter Optik, Phasenkontrast, 3 W NeoLED Beleuchtung und sind auch als Trino erhältlich.
Broschüre BioBlue
BioBlue-Durchlicht-Mikroskope
BioBlue-EVO-Durchlicht-Mikroskope
BioBlue-LAB-Durchlicht-Mikroskope
Preisliste für BlueLine Durchlichtmikroskope:

bScope Mikroskope
Preislich interessante Mikroskope für Biologie, Medizin,, Labore, Universitäten.
Die gut vielseitigen bScope Mikroskope werden intensiv im Bereich der Forschung an weiterführenden Schulen, Universitäten, kleinen Laboren und für tierärztliche Anwendungen und in der Industrie genutzt.
- E-plan, Plan, E-plan IOS und Plan IOS Objektive
- 3 W NEOLED Beleuchtung mit optionalen Akkus
- teilweise mit Köhler Beleuchtung
- Phasenkontrastmodelle
- Metallurgische Mikroskope
- Fluoreszenzmikroskope
Broschüre bScope Mikroskope
bScope Durchlichtmikroskope
bScope Fluoreszenzmikroskope
bScope Metallurgische Mikroskope
Preisliste für bScope Mikroskope:

iScope Mikroskope für Biologie, Medizin,, Labore, Universitäten
Bei Anwendungen für höchste Genauigkeit, ausgezeichnete optische Auflösung und farbliche Reproduzierbarkeit.
Die speziellen multilayer Beschichtung der Optik minimiert unerwünschte Absorptionen und sorgt für klare Abbildungen bei allen Verfahren.
- Binokulare und trinokulare Modelle
- bis zu 5 Objektive: je nach Mikroskop: E-Plan-, Plan-, Phasenkontrast, teilweise unendlich korrigiert
- Objekttisch ohne vorstehende Zahnstange
- Regelbare 3 W NeoLED Köhler Beleuchtung mit internem 100-240 V Netzteil
Broschüre iScope
Preisliste für iScope Durchlicht- und Dunkelfeld- Mikroskope:
Dunkelfeldmikroskope nach Enderlein
Das iScope® Dunkelfeld gibt es in drei Konfigurationen und ist geeignet für Life und biomedizinischen Wissenschaften, Gymnasien, Universitäten.
Das Mikroskop ist ideal für Lebendblut-Analyse und besitzt zusätzlich zu einem normalen Kondensor einen 5W LED Dunkelfeld Cardioid Kondensor.
- S100x Öl-objektiv mit eingebauter Irisblende und 5W LED Dunkelfeld Cardioid Kondensor
- Trinokulare Modelle
- Okulare: 10x/22 mm oder EWF10x/20 mm
- bis zu 5 EPL oder PLi plan Objektive mit unendlich korrigierter Optik
- Objekttisch ohne vorstehende Zahnstange
Broschüre iScope Dunkelfeld
iScope Dunkelfeld Mikroskope nach Enderlein
Polarisations- und Fluoreszenzmikroskope auf Anfrage.
Unser Zugang zur EUROMEX Homepage
Falls Sie etwas bei uns nicht gefunden haben: Sie können über den Link unten auch weitere Informationen und Produkte direkt bei EUROMEX einsehen. Wir sind dann gern Ansprechpartener für zusätzliche Beratung und andere Fragen.
Preislisten Euromex Durchlicht-und Dunkelfeld Mikroskope
Preisliste MicroBlue, EcoBlue, BioBlue Mikroskope
Preisliste bScope Durchlicht-Mikroskope
Preisliste iScope Durchlicht-Mikroskope